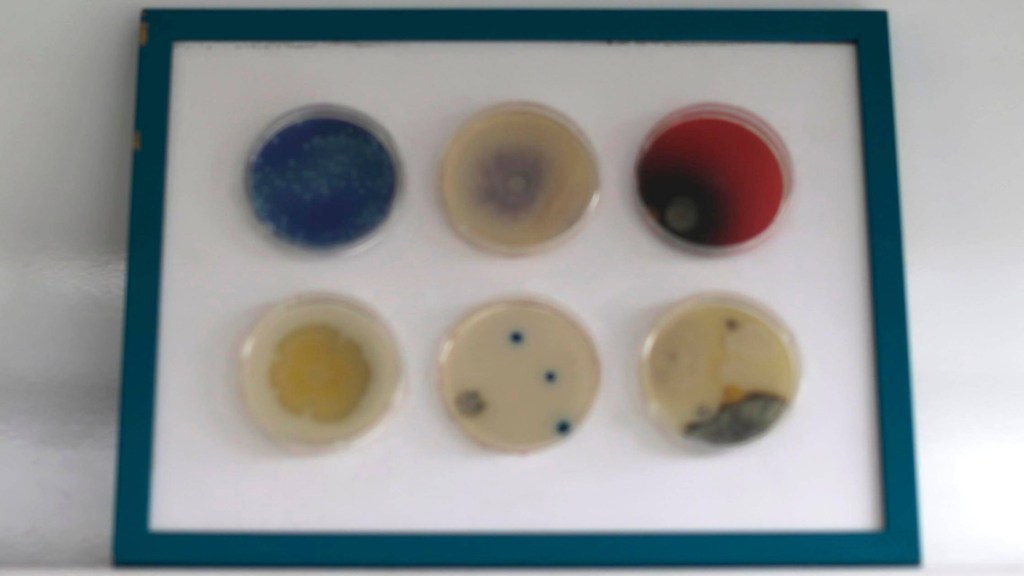

2. Bakterien können in die Haut eindringen
Wenn man eine Blasenentzündung oder Harnwegsinfektion hat, sollte man aufs Pinkeln in der Dusche verzichten. Denn die im Urin enthaltenen Bakterien können über kleine Kratzer oder Risse in die Haut eindringen, was zu Entzündungen führt. Übrigens haben ungefähr 18 Prozent der Frauen Bakterien im Urin, ohne es zu bemerken.